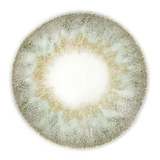
RARE GRAY COLORED LENS ZL32

Premium Colored Lenses by Zlenso
Key Features:
- Superior clarity with Poly Hema 58 colored lenses
- Optimal comfort for all-day wear.
- Sharp vision with 42% water content for eye hydration and freshness.
- Durable design lasting up to 12 months, balancing style and performance.
What's Included:
- 1 Pair of Colored Lenses
- 1 Lens Case
Product Specification:
| Product ID | ZL32 |
| Base Curve | 8.60mm |
| Diameter | 14.2mm |
| Power | P-0.00 |
| Material | HEMA |
| Water Content | 42% |
| Usage Duration | 10+ hours/day |
| Packaging | Blister |
| Certification | CE Certified |
| Expiry | 1 year after opening |